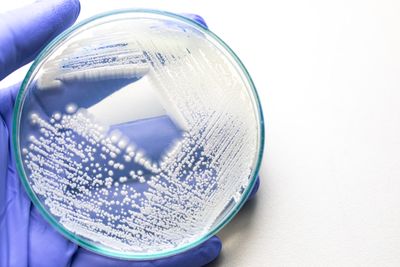
Yeast colonies on agar

Draft genome of Meyerozyma guilliermondii strain vka1: a yeast strain with composting potential
- Published on: September 29 2020
- Source: Journal of Genetic Engineering and Biotechnology
Background
Meyerozyma guilliermondii is a yeast which could be isolated from a variety of environments. The vka1 strain isolated and purified from the organic compost was found to have composting potential. To better understand the genes assisting the composting potential in this yeast, whole genome sequencing and sequence annotation were performed.
Results
The genome of M. guilliermondii vka1 strain was sequenced using a hybrid approach, on Illumina Hiseq-2500 platform at 100× coverage followed by Nanopore platform at 20× coverage. The de novo assembly using dual-fold approach had given draft genome of 10.8 Mb size. The genome was found to contain 5385 genes. The annotation of the genes was performed, and the enzymes identified to have roles in the degradation of macromolecules are discussed in relation to its composting potential.
Annotation of the genome assembly of the related strains had revealed the unique biodegradation related genes in this strain. Phylogenetic analysis using the rDNA region has confirmed the position of this strain in the Ascomycota family. Raw reads are made public, and the genome wide proteome profile is presented to facilitate further studies on this organism.
Conclusions
Meyerozyma guilliermondii vka1 strain was sequenced through hybrid approach and the reads were de novo assembled. Draft genome size and the number of genes in the strain were assessed and discussed in relation to the related strains. Scientific insights into the composting potential of this strain are also presented in relation to the unique genes identified in this strain.